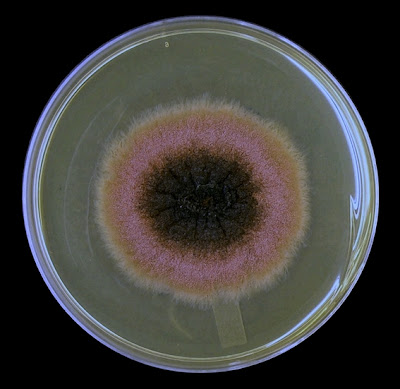

Phomaglomerata(fungus)
Ecology: Phomais yet another ubiquitous, cosmopolitan fungus which is commonly found in soils. As a known plant pathogen, it may also be recovered from infected plant material. Phoma species may be found in the laboratory as an environmental contaminant.
Macroscopic Morphology: Phoma is a rapidly growing fungus which usually reaches maturity within five days. The full development of picnidia may take somewhat longer. Colonies have are usually described as having velvety texture though some sources add they may appear powdery to even woolly. Colonies are usually described as brown to olivaceous and even grey in colour. The reverse is brown to dark brown to black with some species producing a diffusible reddish-brown pigment.
Phoma glomerata - 5 days on SAB at 30oC
Phoma glomerata -Same colony as above at 14 days incubation at 30oC
(Lighting differs from the photo above - difficult to control while trying to capture the true hue)
(Lighting differs from the photo above - difficult to control while trying to capture the true hue)
Microscopic Morphology: Phomaglomerata produces sub-hyaline to hyaline (dark pigmented/brown), septate hyphae. Phomaproduces rather large (~60 µm to 400 µm) pyriform to globose shaped pycnidia[i]. Phialides line the interior of each pycnidium, which produce single celled (rarely two-celled) hyaline (clear) to pale brown, ovoid to ellipsoidal (5-10 µm by 2.5 to 3.0 µm) conidia. The conidia have been described as bi-guttulate (containing 2 oil droplets). Mature conidia are released from the interior of the pycnidium through an ostiole (pore or opening). Phoma glomerata also produces chlamydospores (chamydoconidia) in branched or un-branched chains. The chlamydospores may show both longitudinal and transverse septations (muriform) as is commonly seen in the genus Alternaria.
Note: All photographs which appear below were taken with the Leica DMD-108 digital microscope.
Phoma glomerata - edge of slide culture showing hyphae with the development of pycnidia.
(LPCB, 250X)
Phoma glomerata - pigmented chlamydiospores (chlamydioconidia) extending from hyphae.
(LPCB, 400X, 12 days)
Phoma glomerata - as above. Longitudinal and transverse (muriform) septations are visible within the chlamydospores at this magnification. Free conidia are seen throughout photo.
(LPCB, 400X, 12 days)
Phoma glomerata - muriform chlamydospores.
(LPCB, 400+10X, 12 days)
Phoma glomerata - Pigmented chlamydospores. Both longitudinal and horizontal septations are easily seen in the chlamydospore in this photograph (arrow)
(LPCB, 400+10X, 12 days)
Phoma glomerata - Pycnidia seen as darkly pigmented bodies.
(LPCB, 250+10X)
Phoma glomerata - Three pycnidia showing their brown pigmentation in a LPCB preparation.
(LPCB, 400X)
Phoma glomerata - not the greatest photo example, but I like it. Pycnidium showing a massive release of conidia from within.
(LPCB, 400+10X, 12 days)
Phoma glomerata - as above. LPCB prep, however the cells are so dense that the stain hasn't penetrated throughout the preparation.
(LPCB, 400X)
Phoma glomerata - a pyriform shaped pycnidium is seen with the ostiole at center left. Interior structure of the pycnidium can be somewhat visualized through the wall. Conidiophores line the interior wall of the pycnidium where conidia are produced. Free conida can be seen throughout the photo. Pigmented septate hyphae are also seen in the background.
(LPCB, 400+10X)
Phoma glomerata - three, possibly four pycnidia. Septations are clearly visible in the hyphae at the center of the photograph.
(LPCB, 400X)
Phoma glomerata - possible small ostiole seen (arrow)
(LPCB, 400+10X, 5 days)
Phoma glomerata - Pycnidium with prominent ostiole visible, trailing conidia.
(LPCB, 400+10X, 12 days)
Phoma glomerata (LPCB, 400X)
Pathogenicity: Phomaspecies are known to be pathogenic to some plants however both human and animal infection is infrequent. Phomaglomerata has been implicated in a few documented cases of phaeohyphomycosis. It has also been reportedly isolated from an ulcerated human cornea.
Caution: The pycnidia produced by Phoma species should not be confused with the perethecia suchas those of Chaetomium species or the cleistothecia of Pseudallescheria boydii.
[i] An often flask shaped conidiomata of fungal tissue which is lined on the inside with conidiophores. An asexual fruiting body.
* * *
+5+days.jpg)
+14+days.jpg)
.jpg)












